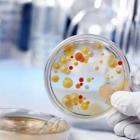
Вредные палочки с красивым названием

Прочие материалы по медицинской тематике
> Статьи > Прочие материалы по медицинской тематике
.jpg)
Посмотрите также:
 Ставим пломбы, лечим зубки К большому сожалению, профессия стоматолога не теряет своей актуальности уже много лет.... |
.jpg&w=140&h=140&zc=1) Не приходит сон ко мне... Бессонница – довольно распространенная проблема, настигающая человека в зрелом возрасте.... |
 «Шишки» на пальцах ног Нередко люди в зрелом возрасте встречаются с появлением такой проблемы, как вальгусная... |
 Способ лечения эрозии – криодеструкция В гинекологии существует несколько способов борьбы с женским заболеванием - эрозией шейки... |
 Как устранить реакцию на золотой стафилококк? Все знают о так называемых юношеских прыщах. Но мало кто знает, что иногда под такими... |


































.jpg&w=140&zc=1)



.jpg&w=140&zc=1)